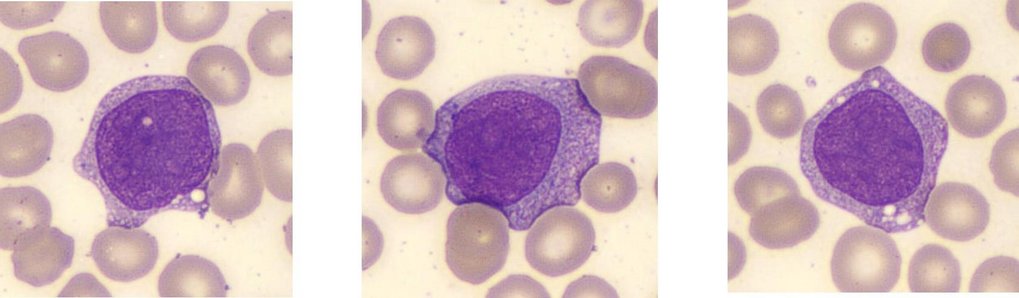
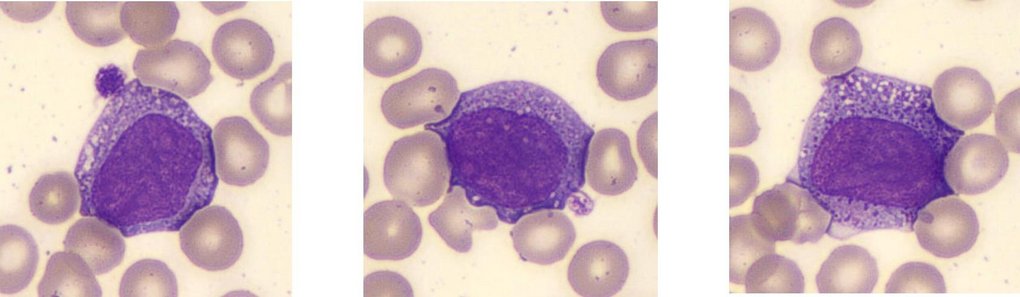
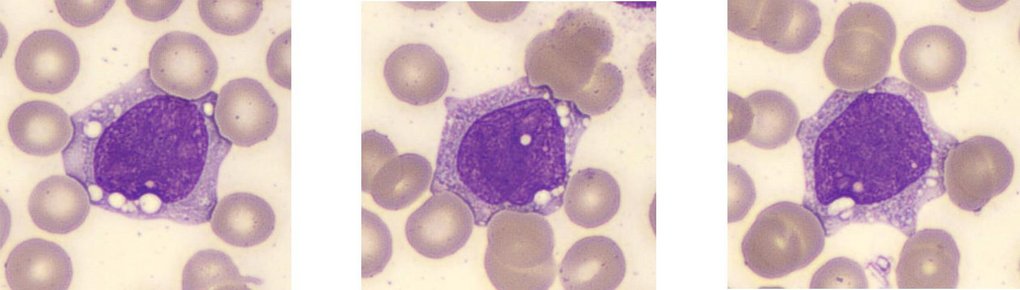
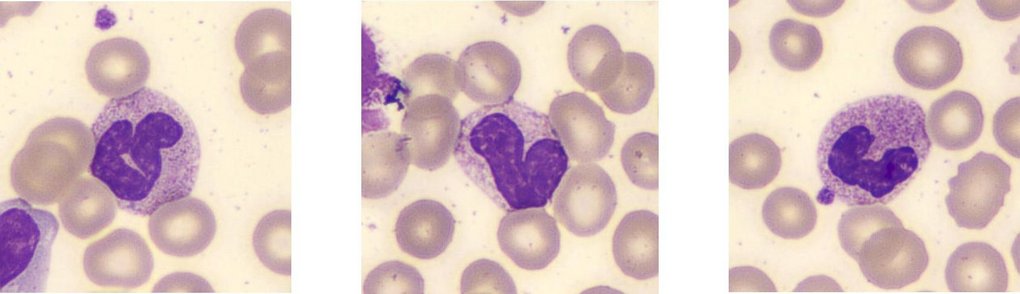
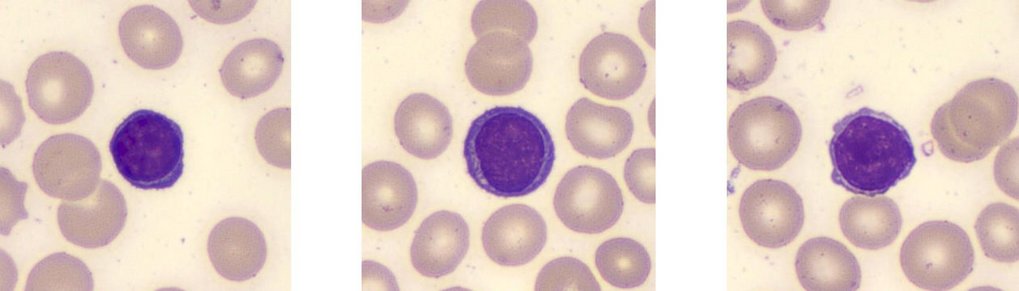

Subscribe now!

Subscribe and receive Heme Insights from the next issue.
A 76-year-old male attended the general practitioner complaining of shortness of breath, bleeding gums and extreme tiredness.
| Automated FBC | |
| WBC 68.3 x 109/L | MCV 85.2 (fL) |
| RBC 4.02 x 1012/L | MCH 29.6 (pg) |
| HGB 119 (g/L) | MCHC 347 (g/L) |
| HCT 0.343 (L/L) | PLT 52 x 109/L |
| Automated WBC Differential | ||
| Parameter | % | x 109/L |
| Neutrophils | 4.8 | 0.71 |
| Lymphocytes | 36.8 | 5.5 |
| Monocytes | 37.5 | 5.6 |
| Eosinophils | 1 | 0.15 |
| Basophils | 19.9 | 2.97 |
The analyzer flagged numerous immature cells, the WBC differential plot was grossly abnormal. A previous result from 6 months prior was normal.
Upon examination of the manual differential, numerous blast cells were noted.
| Manual WBC Differential | |||||
Parameter | % | x 109/L | Parameter | % | x 109/L |
Neutrophils | 1.5 | 1.02 | Promyelocytes | 57 | 38.93 |
Lymphocytes | 18.5 | 12.6 | Myelocytes | 2.5 | 1.71 |
Monocytes | 4.5 | 3.1 | Blasts | 12 | 8.2 |
Eosinophils | 1 | 0.68 | Plasma Cells | 1 | 0.68 |
Basophils | 2 | 1.37 | |||
Blast Cells
Large cells with nucleoli present, some granulation (indicating granulocytic lineage)
Promyelocytes
Monocytes
Neutrophils
Lymphocytes
A preliminary diagnosis of Acute Myeloid Leukemia (AML) possibly AML M2 was made pending further investigations such a genetic markers and immunophenotyping. A bone marrow biopsy and trephine should also be performed. For more information on the classification of AML, see Dohner, Wei, Applebaum et al (2022) Diagnosis and management of AML in adults: 2022 recommendations from an international expert panel on behalf of the ELN, Blood, Vol 140, issue 12.
Acute Myeloid Leukemia (AML) is a rapid onset myeloid neoplasm where a malignant clone of immature myeloid cells overwhelms the normal hematopoiesis process causing an excess of blasts in the bone marrow and peripheral blood with a decrease in the number of red cells and platelets. AML typically affects people aged 60 or over but may also affect younger adults and children. The first stage of treatment (induction) is by a course or courses of intensive chemotherapy in order to kill as many leukemic cells as possible. Once sufficient cells are killed, a second phase (consolidation) of chemotherapy starts in order to maintain remission. Bone marrow or Stem Cell transplant may be offered as appropriate.
Basophils are the least common white cells in normal adults with a normal range of 0- 0.1 x 109/L or (0.5 to 1%). They are characterized by being quite large with large coarse bluish black granules often obscuring the cells 2 lobed S shaped nucleus, the granules contain histamine, heparin and other mediators. These granules are highly acidic containing sulfated glycosaminoglycans and other negatively charged molecules. Due to this basophils exhibit, a strong attraction to basic (cationic) dyes such as methylene blue, toluidine blue and certain components of Wright-Giemsa stain.
The heavily stained granules often make it difficult to see the nucleus clearly see below examples of May Grunwald Giemsa stained Basophils.

Basophils are produced in the bone marrow from hemopoietic stem cells through a series of progenitor stages (granulocyte macrophage progenitors, pro-basophil and basophil progenitors). The process is regulated by specific transcription factors and cytokines including IL-3, C/EBPα GATA-2 and STAT5, with the process from progenitor to mature cell taking 3 – 7 days. After Basophils are released from the marrow into the circulation, they have a life span ranging from a few hours to 1 – 2 days. Basophils and Mast cells share the same function in relation to their role in allergic reactions and are derived from the same early progenitor cells, but basophil differentiation carries on in the marrow whereas the mast cell leaves the marrow as a progenitor and matures in peripheral tissue where they stay.
Basophils are part of the body’s first line of defense against foreign pathogens (the innate immune response) and have a role in allergic reactions and parasitic infections.
In allergic reactions, when the immune system encounters an allergen (e.g., pollen, cat hair), B cells produce a specific IgE antibody against that allergen. Basophils and for that matter Mast cells have IgE receptors on their cell surface which bind with the IgE antibody.
Should the allergen be seen again, the allergen binds to the IgE antibody already attached to the receptors. The Basophil and Mast cell then release the contents of their granules which include histamine IL-3, IL-4 and heparin. The release of histamine causes the typical allergic reaction by the following actions:-
Histamine is a vasodilator and also makes capillaries more permeable, hence causing nasal congestion and a runny nose. Itching and redness are also caused by the vasodilatory action of histamine.
Histamine binds to specific receptors on nerve endings in the nasal mucosa, which causes itching and sneezing.
Basophils are able to promote the TH2 immune response which also enhances the allergic response as well as being important in defending against parasitic infections.
Basophils have a very limited phagocytic capability due to having fewer receptors to recognize foreign particles than on other phagocytic cells.
Basophils play an important role in parasitic infections due to their IgE receptors, which, in turn, when activated, release histamine which enables other immune cells to reach the parasite. Eosinophils are attracted to the parasite due to the signaling from basophils.
A female presents with the following results.
The blood smear is Microcytic/Hypochromic, Target Cell, poikilocytosis.
| WBC 5.62 (10^3/mm3) | MCV 59 (fL) |
| RBC 4.55 (10^6/mm3) | MCH 18.9 (pg) |
| HGB 8.6 (g/dL) | MCHC 32.2 (g/dL) |
| HCT 26.7 (%) | PLT 231 (10^3/mm3) |
What is the best course of action when seeing numerous features as below in the tail of the smear with the following results?
| FBC | |
| WBC 8.60 (10^3/mm3) | MCH 29.6 (pg) |
| RBC 3.21 (10^6/mm3) | MCHC 32.6 (g/dL) |
| HGB 9.5 (g/dL) | PLT 222* (10^3/mm3) |
| HCT 29.1 (%) | RDWsd 40.3 (fL) |
| MCV 90.7 (fL) | RDWcv 12.3 (%) |
a) Ignore the features as they are in the tail of the smear.
b) Manually check the sample for clots. Comment on the fact that the platelet count may be underestimated and request a repeat.
c) Query if Microfilaria is present.
The Answer: b)
Comment on the fact that the platelet count may be underestimated and request a repeat.
Numerous fibrin clots and platelet clumps were noted particularly in the tail of the smear. Due to the nature of such features the fibrin clots will be dragged to the tail of the film during smearing.
Small clots may be present in the sample. A fresh sample needs to be requested to confirm the platelet count.
The cell shown is known as a Band cell or Stab cell; if numerous are present in the blood smear, it is an indicator of infection or inflammation. Gross red cells abnormalities with large platelets and platelet clumps in a Beta Thalassemia patient. Platelet production and their function in hemostasis and infection.
Bibliography
Editorial Team
Kelly Duffy, Andrew Fisher, HORIBA UK Limited

